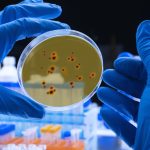

De acordo com o professor de Yoga Ravi Kaiut, é possível usar o Yoga para desenvolver a resiliência
Por: Ravi Kaiut/MF Press
A resiliência é uma habilidade fundamental para enfrentar os desafios e adversidades da vida, trata-se da capacidade de se adaptar e se recuperar diante de situações difíceis, mantendo uma atitude positiva e persistindo na busca por alternativas.
No entanto, na sociedade atual, desenvolver resiliência tornou-se um grande desafio, a cultura do imediatismo, aliada à busca constante por conforto e gratificação instantânea, tem levado as pessoas a terem dificuldade em lidar com frustrações e enfrentar situações complicadas, a pressão social e a ênfase na perfeição também contribuem para enfraquecer a resiliência, pois as pessoas tendem a se abalar mais facilmente com falhas e críticas.
Diante dessa situação, cada vez mais novas ferramentas têm sido buscadas para auxiliar no desenvolvimento da resiliência, uma das que mais utilizadas é o Yoga, a prática milenar ganhou milhares de adeptos nos últimos tempos, de acordo com o professor de Yoga, Ravi Kaiut, a busca por saber como lidar com as adversidades é uma das principais motivações para esse aumento.
“Ao contrário do que muitos pensam, o Yoga não foca exclusivamente no corpo, mas utiliza uma abordagem integrada corpo-mente que ajuda a encontrar uma nova forma de lidar com os problemas, a controlar o estresse e utilizá-lo positivamente”.
“Por meio de posturas físicas (asanas), exercícios de respiração (pranayama) e meditação, o yoga fortalece tanto o corpo quanto a mente, ajudando a lidar melhor com os desafios da vida, ele promove a consciência do momento presente e proporciona um espaço de autocuidado e autorreflexão, permitindo o cultivo de uma mentalidade positiva e a construção de uma base sólida para enfrentar as adversidades com calma, equilíbrio e serenidade” Explica Ravi Kaiut.
Foto de Capa: Forbes